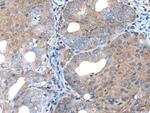
UNC5B Antibody in Immunohistochemistry (Paraffin) (IHC (P))

Search
Invitrogen
UNC5B Polyclonal Antibody
{{$productOrderCtrl.translations['antibody.pdp.commerceCard.promotion.promotions']}}
{{$productOrderCtrl.translations['antibody.pdp.commerceCard.promotion.viewpromo']}}
{{$productOrderCtrl.translations['antibody.pdp.commerceCard.promotion.promocode']}}: {{promo.promoCode}} {{promo.promoTitle}} {{promo.promoDescription}}. {{$productOrderCtrl.translations['antibody.pdp.commerceCard.promotion.learnmore']}}

Please note: We are reviewing Western blot images included in the antibody testing data in our catalog, including those provided by third parties. Unless expressly labeled or annotated as “raw-unedited”, Western blot images included in the antibody testing data in our catalog may have been edited, optimized or otherwise adjusted for presentation.
产品信息
PA5-67631
种属反应
已发表种属
宿主/亚型
分类
类型
抗原
偶联物
形式
浓度
规格
纯化类型
保存液
内含物
保存条件
运输条件
RRID
产品详细信息
Predicted to react with Mouse samples.
靶标信息
Receptor for netrin required for axon guidance. Mediates axon repulsion of neuronal growth cones in the developing nervous system upon ligand binding. Axon repulsion in growth cones may be caused by its association with DCC that may trigger signaling for repulsion. It also acts as a dependence receptor required for apoptosis induction when not associated with netrin ligand. Mediates apoptosis by activating DAPK1. In the absence of NTN1, activates DAPK1 by reducing its autoinhibitory phosphorylation at Ser-308 thereby increasing its catalytic activity.
仅用于科研。不用于诊断过程。未经明确授权不得转售。
生物信息学
蛋白别名: C. elegans; Netrin receptor UNC5B; p53-regulated receptor for death and life protein 1; p53RDL1; Protein unc-5 homolog 2; Protein unc-5 homolog B; unc-5 homolog 2; unc5 homolog 2
基因别名: 6330415E02Rik; A630020F16; D10Bwg0792e; P53RDL1; UNC5B; UNC5H2; UNQ1883/PRO4326
UniProt ID: (Mouse) Q8K1S3
Entrez Gene ID: (Mouse) 107449



